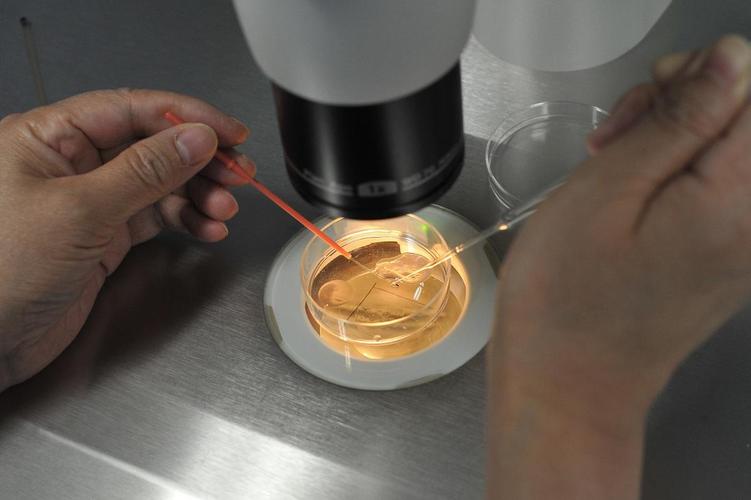

老陈是我的朋友,他在省城一家建筑设计院担任结构工程师,已画了快十五年图纸。去年秋天,他突然在微信上给我发来一张婴儿照片,配文是“当爹了,闺女,六斤八两”。而后他盯着屏幕愣了好几秒,因为据我所知,他跟嫂子只为要个孩子,就已折腾了将近八年。
老陈与嫂子的过往经历,依我之见,简直就犹如是一部实实在在的“备孕失败详尽全书”。刚成婚的头两年时间里,他俩都处于忙碌状态,认为孩子这件事情顺其自然便行了。待到年龄来到三十出头之际,双方家中老人开始进行催促,他们这才重视起来。戒掉香烟与酒水、开展跑步及健身活动、测量排卵期,一切能思索到的科学备孕办法均已尝试过,然而嫂子的肚子却一直毫无动静。那种每个月都满怀期望最终却落空的感受,老陈讲道,恰似钝刀子割肉一般,久而久之,人都变得麻木不仁了。
到老医院进行一下检查,发现两边都存在着一些状况。老陈患的是轻微的弱精症,嫂子的输卵管也并非足够通畅。医生给出如下建议,要不要尝试一下人工授精,它隶属最基础、创伤最小的辅助生殖方式范畴。老陈当时心里想着,既然有科学技术予以协助,那肯定要比自己盲目地折腾强出许多对吧于是他们开启了漫长的跑医院行程,进行监测卵泡,打针,而后开展人工授精操作。连续做了三次,每一次均是以十四天后验孕棒上那道孤零零的杠作为最终结果告终的。
那段日子里,老陈最为惧怕的便是回到家中。嫂子那佯装出来的轻松模样,致使他内心愈发不好受起来。他跟我讲,有一回他在半夜苏醒,瞧见嫂子独自坐在客厅内,对着窗外的路灯发愣。那个背影,直至如今他都难以忘怀。后来嫂子同他商议,人工授精的成功率原本就不高,要不咱们直接去做试管婴儿吧?老陈查阅了诸多资料,明白这又是一条更耗费钱财、更承受痛苦的途径,然而望着嫂子眼中那仅存的一丝光亮,他咬了咬牙,说道,行,咱们做。
为什么有的人试管一次就成功
而是当真正着手去做试管的时候,老陈方才发觉,此件事情与他预先 envision 的相较,那是有过之而无不及地繁杂。他们挑选了一家于省内拥有良好口碑的生殖中心,就此开启了首个周期。先是进行促排卵操作,相继提卵子采集子与精子,接着便是满心焦灼地去等候胚胎培养之后得出的结果。头一回,成功配制成了 3 个胚胎,用于鲜胚移植的有两个,然而并未成功着床。剩余的之中有一个培育成囊胚,同样宣告失败。头一次做试管竟是这般糊里糊涂地以失败告终。医生在进行复盘分析时表示,或许是胚胎自身质量欠佳,又兴许是子宫内部环境尚未调理至最为理想的状态。这么个情况使老陈处在十分困惑的状态之中,他对各种各样的论坛展开了浏览,从中看到存在一些人一次就达成了相应的事情,可为何到了自己这里就变得这般困难呢?难道说实打实的是运气方面出现的问题吗?
第一次失败过后,嫂子的情绪长时间处于低落状态。老陈不敢再提及这件事情,然而心里却憋着一股闷火。他并不相信这个邪门的状况。恰好单位有个刚入职的年轻同事,在闲聊期间讲起他表姐同样是多年未能怀孕,最终在一位医术高超的医生那里成功看好了。同事还说,那位医生不但看重医术,更加注重为每一个人制定“私人定制”的方案,并且还建议他表姐做了一项非常新颖的遗传学检查。老陈听闻后,心思再次活跃起来。他偷偷地记下了医生的名字以及医院,回到家后与嫂子商议,要不,换个地方,再次尝试一回?
第三代试管婴儿是什么意思
这回呀,老陈跟嫂子变机灵了。经由朋友推荐,他俩挂了省妇保生殖遗传科的号。给他们看病的是位四十多岁的女医生,这位医生说话不紧不慢,询问得极其详尽,把他俩前几年的检查报告、每次治疗的经过,连平时的生活习惯都逐一问了个通透。最终呢,医生提议他们去做一项更深入的基因检测。检测结果表明,嫂子的染色体存在一种细微的平衡易位,这便是致使他们反复流产以及胚胎质量欠佳的根源所在,然而常规检查根本没法发现。

医生讲,你们先前的状况,属于那种找不出明确缘由的反复种植失败情形。如今,已然找到了病根,那便需要借助更具针对性的技术手段来予以解决。她给他们推荐去尝试第三代试管婴儿技术,这技术其实就是胚胎植入前遗传学检测。简单来讲,就是在把胚胎往子宫里移植之前,先针对胚胎开展遗传学方面的筛查工作,从中去挑选出染色体呈现正常状态的胚胎来实施移植,如此这般能够大幅度提升成功率的说,与此同时还能够降低流产的风险。直至这时老陈才弄明白,原来试管婴儿技术一直在持续进步,他们之前的状况就仿佛是在迷雾当中开车一样,而现如今总算有了一张如同导航地图般的指引。
在第三代试管婴儿技术予以的助力之下 ,老陈跟嫂子开启了第二个周期。这一回 ,尽管促排卵 、卵子采集的进程依旧艰辛 ,可老陈与嫂子的心态有所不同了。他们清楚每一步所从事的事情 ,明白为何要如此去做。特别是在知晓培育出好几个囊胚 ,并且送检之后 ,有2个囊胚的染色体是全然正常的 ,老陈握住嫂子的手 ,发觉嫂子的手心里满是汗水 ,但却是温热的。
做试管婴儿的全部流程
移植那日,老陈特地请了假,自进入手术室直至出来,不过十几分钟,而后便是漫长的十四日等待,老陈讲那十四日比过往八年都更难熬,他们谨小慎微,不敢有丝毫举动,亦不敢提前检测,至第十四日,一同前往医院抽血,在拿到 HCG 数值报告的瞬间,嫂子未哭,老陈却不禁眼眶泛红,数值理想,意味着胚胎成功着床,接下来是通过 B 超查看胎心,看到屏幕上那个微小的、跳动的心脏,老陈称,在那一刻他才真切地感觉到,一个新生命即将来临。
嫂嫂于后面的孕期阶段,鉴于存有先前的过往经历,几乎是以数着日子的方式度过那段时日的,每一回的产检都好似是在历经闯关一般,诸如NT、无创DNA以及大排畸之类,每一项所检查得出的指标均会牵动着他们一家人的神经,还好的是所有过程都顺顺利利的,去年秋天之际,他们家的女儿顺产出世,母亲与女儿都平安无事,老陈在位于产房的外面之处,从护士的手里接过了那个体型小小的人儿,那种感觉就仿佛手里所捧着的,乃是他们一家三口历经这些年以来所有的期盼以及坚持。
前几日,我去往他家看望孩子,那小家伙生得白白净净,眼睛乌黑且明亮。老陈怀抱着闺女,向我絮叨他一路走来的感受。他讲,往昔一直觉得生育孩子是件顺其自然之事,没料到需借助这般高深精湛的科学技术。他尤为感激那位建议他们开展遗传学检测的医生,亦庆幸自己与嫂子未曾在首次失败之后就选择放弃。
老陈所拥有的经历,着实令我内心的感触相当深刻。他朝着我讲述道,要是存在朋友正于这条道路之上进行挣扎,他期望去分享一些属于自己的体会,其一,绝对不要独自一人闷头去查阅资料,必须寻找到专业精准的医生以及医院去寻求帮助,他们能够给予你更为科学合理的判断。其二,要是出现反复失败的情况,务必要与医生展开沟通交流,查看是不是需要开展更深层次的遗传学筛查,探寻到根本原因远比盲目地不断重复尝试要重要许多。其三,在这个特定的过程当中,夫妻两个人需要彼此相互支撑彼此相依,那种承受着煎熬与压力的感受,唯有历经过的人才能够真正地透彻理解。
此刻望着老陈一家三口呈现出的幸福模样,再去追忆他往昔那些失眠的夜晚,那些置身于医院走廊中的等待,着实感觉一切都是值得的。科学技术的确是在助力像他们这样的家庭,去达成那个看似简易、可实际却并非易事的梦想。要是你或者同你关系紧密的朋友也正历经恰似这般的困扰,不妨增添些许耐心,并且再多去了解一下持续进步的医学技术,有时候,柳暗花明就在邻近的下一个路口处。
各位友人,你们自身或者身旁之人有过相似这般的经历吗,欢迎于评论区域分享你们的那些故事,或者向老陈一家送上一个点赞,祝愿小宝贝能够健健康康快快乐乐地成长,也千万不要忘记进行收藏以及转发,说不定你的一个微不足道的小小举动,就能够对正处于迷茫之中的人起到帮助作用。